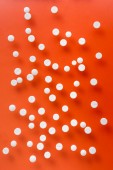

Widok z góry rozproszone czerwonego piasku na pomarańczowej powierzchni

Informacje o pliku:
| Numer pliku: | 0101185138564 |
| Typ pliku/format: | Zdjęcia ( JPG ) |
| Rozdzielczość: | 4912x7360 (41,59x62,31 cm 300 dpi) |
| Kategorie: | |
| Autor: | VadimVasenin |